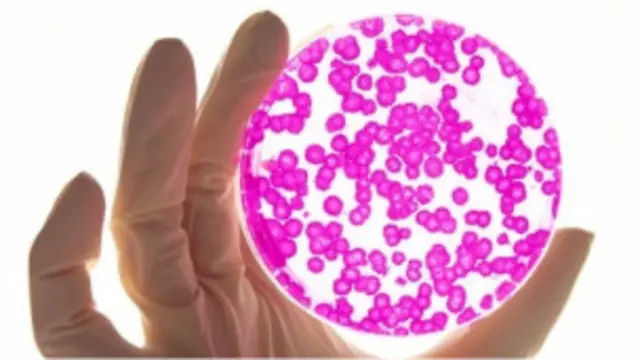

MS hastalarına kök hücre tedavisi
Kaynak, spl
Avrupa'daki araştırmacılar, multipl skleroz (multiple sclerosis - MS) hastalarına uygulanacak kök hücre tedavisinin ilk büyük denemesine başlıyor.
Kesin tedavisi olmayan ve merkezi sinir sistemini etkileyen MS, hastaları felçli bırakabiliyor.
Araştırmacılar, "hastanın kendi iliğinden alınan hücrelerin enjekte edilmesi hastalığın beyin ve omuriliğe verdiği zararı yavaşlatabilir ve hatta geri döndürebilir mi?" sorusunun cevabını arıyor.
Deneme sürecine, Avrupa'nın çeşitli ülkelerinden 150 MS hastası katılacak.
Hastaların kemik iliğinden alınacak kök hücreler, laboratuvar ortamında büyütülecek ve hastanın kanına yeniden enjekte edilecek.
Kök hücrelerin beyne ilerleyeceği ve MS'in verdiği zararı tamir edeceği umuluyor.
Londra'daki Imperial College Üniversitesi'nden doktor Paolo Muraro, "Kök hücrenin etkin bir tedavi olabileceğine ilişkin oldukça güçlü laboratuvar kanıtları bulunuyor." dedi.
Araştırmanın fon sağlayanları arasında olan İngiltere MS Derneği ise henüz işe yaradığı kanıtlanmamış kök hücre tedavisinin erişime sunulmasına ilişkin kaygılarını da ifade etti.
Deneme başarılı olursa bile, etkin bir tedavinin geliştirilmesi yıllar sürebilir.
Dünyada üç milyon, İngiltere'de ise 100 bin MS hastası olduğu düşünülüyor.
Hastalığa bağışıklık sisteminin vücuda saldırması ve beyin ve sinir hücrelerinde bulunan miyelin isimli maddeye zarar vermeleri yol açıyor.








